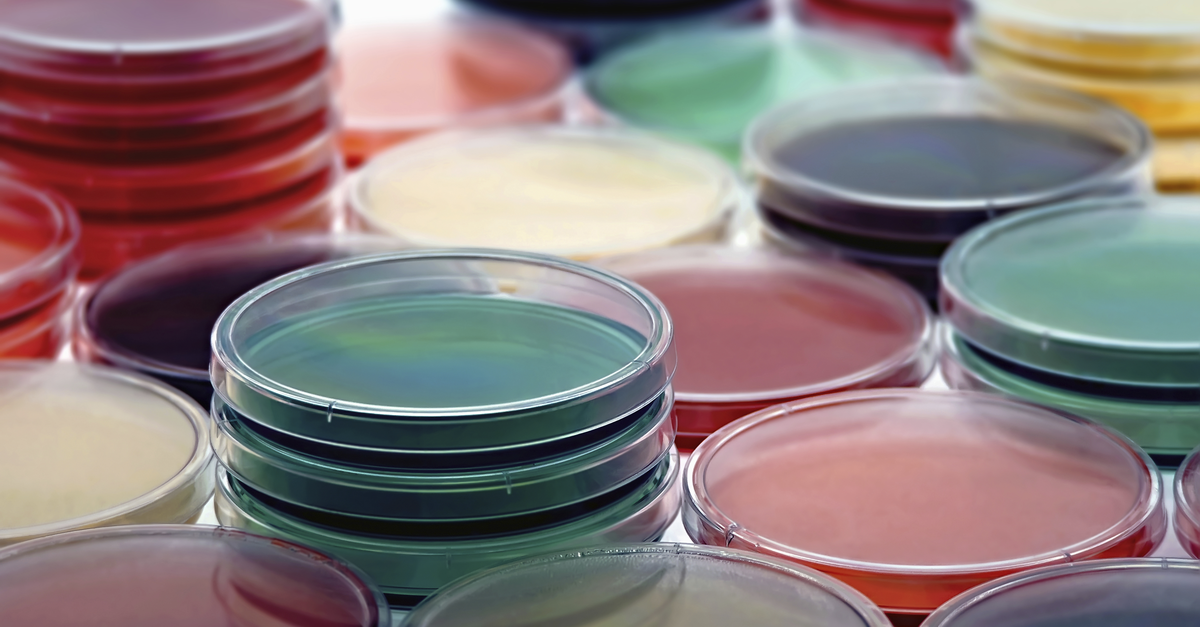
Petri Plates Collection

The government announced further restrictions on 27 March based on public health guidance, including a restriction on leaving your home except in specific circumstances. These restrictions were set to expire on 12 April but were later extended until 5 May.
The government has asked that everyone stay at home until 5 May, except for the following reasons:
- to travel to and from work, or for purposes of work, only where the work is an essential health, social care or other essential service and cannot be done from home;
- to shop for essential food, beverage and household goods or collect a meal;
- to attend medical appointments and collect medicines and other health products;
- for vital family reasons, such as providing care to children, elderly or vulnerable people;
- to take brief individual physical exercise within 2 kilometres of your home; and
- for farming purposes - that is, food production or care of animals.
The government has provided a list of essential service providers under the new public health guidelines. If you carry out an activity that is necessary for the continued provision of an essential service by another organisation or you are part of an essential supply chain, the government has advised that you should continue to carry out that activity and to the maximum extent possible, that should be done remotely. A revised retail list has since been published, and there are a number of retailers who are limited to offering emergency call-out or delivery services on that basis only.
Regulations were implemented on 8 April which remain in place until 5 May. If you are not engaged in the provision of essential services, then you are not permitted to travel to and from work until 5 May. The minister for health may make further regulations where necessary, to deal with the public health risks arising from the spread of Covid-19. Their purpose is to prevent, limit, minimise or slow down the spread of Covid-19.
Anyone who contravenes, obstructs, interferes with or impedes a member of the Garda Síochána in the course of exercising a power under these regulations may be found guilty of an offence which on summary conviction can lead to a fine of €2,500 or imprisonment for a term not exceeding six months, or both.
Where offences are committed by a corporate body and it is proved that the offence was committed with the consent or connivance, or was attributable to any wilful neglect, of a director, manager, secretary or other officer of the company, or someone purporting to act in that capacity, that individual, as well as the company, will be guilty of an offence.
As per previous guidance all employees should work remotely from home, if at all possible. Employers should continue to monitor the situation as it develops and prepare their businesses by reviewing their policies and procedures and ensuring that they have a contingency plan in place. Companies should also consider whether the government income supports can provide assistance to them during these challenging times. See our Out-Law Guide: income supports for employers and employees in Ireland.
The HSE and Irish government have published guidance on protecting yourself from Covid-19 and minimising the spread of infection, which is being updated regularly.
What duties do Irish employers have to protect their employees?
On 27 March, the Taoiseach updated the list of essential retail outlets that can remain open. The National Public Health Emergency Team has recommended that all non-essential retail outlets should close to members of the public, and that all other retail outlets implement physical distancing measures.
Employers who remain open have a legal obligation to ensure the safety, health and welfare at work of their employees under the Safety, Health and Welfare Act (the 2005 Act). Employers should carry out a risk assessment to identify the risks of a coronavirus outbreak at work, and implement steps to minimise that risk.
Employers should continue to monitor the situation as it develops and prepare their businesses by reviewing their policies and procedures and ensuring that they have a contingency plan in place.
Employers should have a plan setting out the steps that they are taking to try to protect against an outbreak at work and what steps should be followed if there is an outbreak.
Basic measures employers may implement include:
- displaying the posters which have been produced by the HSE to raise awareness of measures preventing the spread of Covid-19;
- carrying out a risk assessment, ensuring good hygiene practices in the workplace and training employees on recognising Covid-19 symptoms and the steps they should take if they suspect they may have come into contract with someone who is infected;
- providing alcohol-based hand sanitiser, hand washing facilities and tissues in the office;
- considering whether employees need to be provided with preventative protective equipment;
- keeping up to date with the latest public health guidance and local government advice as well as World Health Organisation (WHO) updates and communicating these to employees;
- updating any policies and procedures which may be affected by an outbreak of coronavirus, including sickness, absence and agile working policies;
- reducing or cancelling non-essential travel and instead conducting meetings via video link; and
- asking employees to report to HR if they have been to a high-risk destination or if they have been in contact with someone who has been to a high-risk destination regardless of whether they are exhibiting symptoms.
What duties do Irish employees have?
Under the 2005 Act an employee, while at work, must notify their employer or the employer's nominated registered practitioner if they become aware that they are suffering from any disease or physical or mental impairment which affects their performance of work activities that could give rise to risks to the safety, health and welfare of others at work. The duty is on the employee to protect themselves and others.
When must employees self-isolate or work from home?
Many employers have already taken steps to facilitate home working and the government has advised that only essential service providers should be travelling to and from work. All work should be carried out remotely from home, where possible.
The HSE has advised self-isolation where an employee has developed symptoms of coronavirus, is waiting to get tested, is waiting for test results, has any cold or flu-like symptoms or has coronavirus. Self-isolation means staying indoors and avoiding contact with other people.
An employee who has developed symptoms should be on sick leave, and therefore not working.
If the employee is asymptomatic, it may be possible for the employer to ask the employee to work from home.
Are symptomatic employees entitled to sick pay?
Whether an employee is entitled to sick pay from their employer will depend on the employer's sick pay policy and whether the employee has symptoms.
If the employee has symptoms they will be on sick leave, and whether they will be entitled to pay from their employer will depend on the employer's sick pay policy. In Ireland, there is no legal obligation for an employer to pay an employee while on sick leave, unless the employer has agreed to do so in a contract or policy. If sick pay is paid, it tends to be paid for a capped period of time and net of any benefit receivable from the Department of Employment Affairs and Social Protection (the Department).
If the employee is not entitled to sick pay from their employer, they may still be entitled to a benefit - such as Illness Benefit - from the Department if on medically certified sick leave. As noted above, even if any sick pay is payable from the employer to the employee it may be net of this benefit.
The government has introduced a Covid-19 Illness Benefit. The payment when first introduced was at a rate of €305 per week but was increased to €350 per week on 24 March. Covid-19 Illness Benefit will be paid for a maximum of two weeks where a person is self-isolating, and for a maximum of 10 weeks if a person has been medically diagnosed with Covid-19. If a person has been certified for less than 10 weeks, they will be paid for the duration of their certificate. The Covid-19 Illness Benefit is paid from day one of the certified leave due to Covid-19.
If an employee is applying for the Covid-19 Illness Benefit they must:
- be self isolating on the instruction of a doctor or the HSE or diagnosed with Covid-19;
- be absent from work and confined to home or a medical facility;
- have been in paid employment immediately prior to claim; and
- submit, on request, evidence of absence from work.
If an employer requires an asymptomatic employee who is considered an essential worker under the current government guidance to stay at home, how should their leave and pay be treated?
As these employees are not "sick", it is unlikely that they will be eligible for sick leave. Instead, the employee is likely to be on a period of leave. This leave is likely to need to be paid at full pay by the employer, unless the employer has a contractual right to place the employee on a period of unpaid leave - such as a contractual lay off provision – or some other arrangement is agreed with the employee. Any such period should therefore be kept to a minimum - i.e. no longer than the recommended two week period of self-isolation. Note that if the employee becomes symptomatic during or after that period the above provisions should apply.
Specific legal advice should be sought where necessary in relation to the coronavirus and leave entitlements, as the situation is changing daily.
Employees who are laid off temporarily, without pay, due to a reduction in business activity because of the outbreak, can apply for the Covid-19 Pandemic Unemployment Payment. Employees who are put on short-term working by their employer due to a reduction in business activity related to Covid-19 may apply for a Short-time Work Support.
Where an employee voluntarily self-isolates without discussing this with the employer there may be more scope for considering such leave to be unpaid, although this will depend on the circumstances.
Can an employer require an employee to undergo medical examination?
The right to have employees medically examined will depend on the particular contract or policy that the employer has in place. Where such a provision is in place, and where an examination is justified taking into account all of the circumstances, the employee cannot reasonably refuse to be medically examined.
Where no such contractual or policy provision exists, and the employer believes that there is a need to medically examine the employee in light of the status of the risk, then this should be conveyed to the employee and explained that it is in the best interests of the employee - and their colleagues - to agree to a medical examination to assess whether they are symptomatic.
Information gathered about the health of an employee will be classified as "special category data" under the General Data Protection Regulation (GDPR) and Data Protection Acts 1988-2018. It should be handled as such, and kept strictly confidential.
Employers must be careful not to single out certain employees based on their nationality, racial or ethnic origin as this could lead to a risk of discrimination. Further, any communication confirming that an employee has Covid-19 should not identify the employee.
Can an employer require all staff and visitors to the building to fill out a questionnaire requesting information on their recent travel history concerning countries affected by the virus, and medical info?
The Data Protection Commission (DPC) has issued guidance which advises that employers have a legal obligation to protect the health of their employees and maintain a safe place of work. In this regard, and in the current circumstances, employers would be justified in asking employees and visitors to inform them if they have visited an affected area and/or are experiencing symptoms.
Implementation of more stringent requirements, such as a questionnaire, would have to have a strong justification based on necessity and proportionality and on an assessment of risk. This should take into consideration specific organisational factors such as the travel activities of staff attached to their duties, the presence of vulnerable persons in the workplace, and any directions or guidance of the public health authorities.
Specific legal advice should be sought where necessary in relation to Covid-19 and leave entitlements, as the situation is changing daily.
Research by Jason McMenamin of Pinsent Masons, the law firm behind Out-Law.